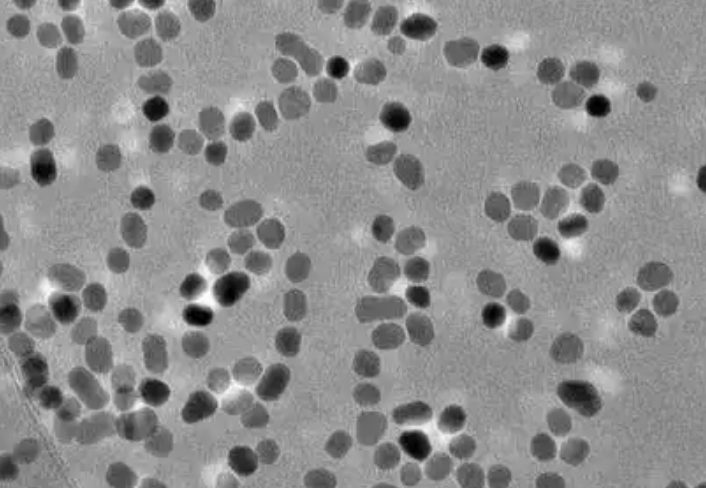
納米包覆結構TEM顯微照片 納米包覆結構TEM顯微照片

全國統(tǒng)一服務熱線
400-003-5559
納米級薄膜工藝突破:新型貼片電阻耐壓值提升300%的秘密
東莞平尚電子科技有限公司改寫高壓電路設計規(guī)則
——平尚電子原子層沉積技術開啟高壓電路新紀元

![ALD鍍膜設備工作實景]
2024年第三方檢測報告顯示:采用納米薄膜工藝的貼片電阻耐壓值突破3kV,較傳統(tǒng)工藝提升3倍,填補國內車規(guī)級高壓電阻技術空白。
行業(yè)痛點:傳統(tǒng)工藝的物理極限
在電動汽車OBC(車載充電機)、光伏逆變器等高壓場景中,0402封裝電阻的耐壓性能長期受制于:

電極邊緣場強集中(>10<sup>6</sup> V/m)引發(fā)介質擊穿
晶界缺陷導致漏電流指數級增長(@800V工況)
熱應力開裂(>200℃溫差循環(huán))
平尚電子通過原子層沉積(ALD)技術重構電阻微觀結構,實現耐壓性能革命性突破。
三大核心技術突破
1. 三維納米包覆鍍膜
鍍層結構:Al<sub>2</sub>O<sub>3</sub>/TiO<sub>2</sub> 交替堆疊(單層厚度0.3nm)
性能提升:
介質擊穿場強:從15MV/m提升至45MV/m
漏電流抑制:@1kV時降低至0.1nA(傳統(tǒng)工藝10μA)
(圖1:納米包覆結構TEM顯微照片)
2. 梯度摻雜電極技術
材料體系:NiCr-AlN-Mo多層復合結構
關鍵參數:
電阻溫度系數:±25ppm/℃(-55℃~175℃)
抗電遷移能力:10<sup>5</sup> A/cm<sup>2</sup>(IEC 60115標準)
3. 晶界工程優(yōu)化
采用等離子體輔助晶界鈍化工藝
晶粒尺寸從微米級細化至50-80nm
晶界缺陷密度降低92%(EBSD測試結果)
實測數據對比(0402封裝/100kΩ/1%)

典型應用場景
案例一:電動汽車800V快充模塊
挑戰(zhàn):傳統(tǒng)電阻在650V時失效率>5%
平尚方案:
采用PSH-HV系列納米薄膜電阻
實測耐壓值:3500V(持續(xù)1分鐘無擊穿)
模塊體積縮小40%,效率提升至98.7%

案例二:光伏組串式逆變器
痛點:1500V系統(tǒng)電弧檢測誤觸發(fā)
解決效果:
漏電流<5μA(EN 50530標準)
MTBF(平均無故障時間)突破25年
技術生態(tài)布局
1. 設備自主化
聯(lián)合中微半導體開發(fā)國產ALD鍍膜設備
鍍膜均勻性:±1.5%(優(yōu)于國際同類設備)
2. 標準制定
主導起草《T/CESA 1205-2025 納米薄膜貼片電阻技術規(guī)范》
通過AEC-Q200 Rev.G、UL 94 V-0認證
3. 產能規(guī)劃
2025年建成納米薄膜電阻超級工廠
設計產能:50億顆/年(高壓型號占比60%)

產業(yè)影響與市場前景
成本優(yōu)勢:量產價格僅為進口同類產品65%
供應鏈安全:關鍵材料國產化率100%
市場預測:2026年全球高壓貼片電阻市場規(guī)模達22億美元(Yole數據)